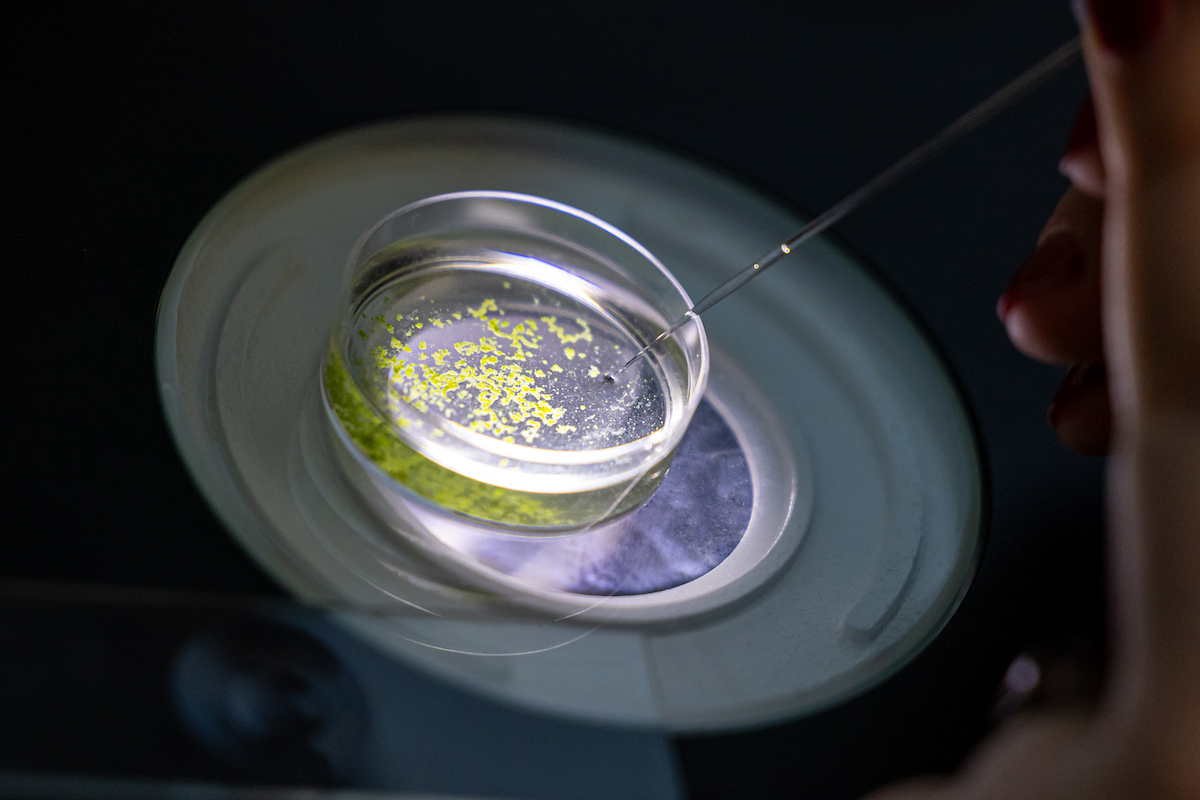
placeholder

Environmental Health & Safety

Environmental Health & Safety
Protecting the health, safety, and environment of the UNC Asheville campus community — from laboratories to classrooms to all campus workplaces.
Emergencies & Incidents
Environmental, Health and Safety is charged with ensuring the operations of the University are performed in a manner that maintains the safety of faculty, staff, students, visitors, contractors and the community. EHS manages compliance with environmental, health and safety regulations including but not limited to the U.S. Department of Labor, Occupational Health and Safety Administration (OSHA)/ North Carolina State OSHA; U.S. Environmental Protection Agency (EPA)/ North Carolina Department of Environment and Natural Resources (NCDENR); U.S. Department of Transportation (DOT); and the U.S. Nuclear Regulatory Commission (NRC).
Our goal is to develop a culture of proactive thinking, planning and education to promote the safety of people and protection of the environment in all campus operations.
For Campus Emergencies
For any on-campus emergency, contact Campus Police immediately at (828) 232-5000 or dial 5000 from any campus phone — off-campus, dial 911. All workplace incidents, no matter how minor, must be reported to your supervisor and documented through an incident report. EHS must be notified immediately of any fatality, hospitalization, amputation, or loss of an eye at (828) 258-7692; after hours, reach EHS through Campus Police.
Academic Safety
EHS supports safe teaching and research environments across labs, studios, shops, and off-campus academic activities. The programs below address specialized hazards found in academic settings at UNC Asheville.
Laboratory Safety Overview

Laboratory Safety Overview
The starting point for all campus lab workers — chemical hygiene plans, biosafety levels, standard operating procedures, and required training.
Biological Safety
Biosafety levels, risk group classifications, select agent regulations, and safe handling of biological materials on campus.

Chemical Safety
Chemical hygiene, storage, handling, SDS resources, and procedures for working safely with hazardous chemicals.

Hazardous Waste
Proper labeling, segregation, storage, and disposal of all hazardous waste streams generated on campus.

Radiation Safety
Radioactive material licensing, use authorizations, monitoring, and safe practices for radiological work.

Machine Shop Safety
Safe operation of machine tools, required training for shop users, PPE requirements, and authorization procedures.

Theatrical Arts Safety
Safety guidance for scene shops, rigging, electrical, pyrotechnics, and production environments in the performing arts.

Visual Arts Safety
Hazard guidance for studios, printmaking, ceramics, metals, and other visual arts disciplines and materials.

Robot & Robotic Systems
Safety requirements for design, operation, and maintenance of robotic systems in labs and academic settings.

Laser Safety
Safety requirements for the use, control, and maintenance of Class 3B and Class 4 laser systems in labs and academic settings.

Off-Campus Activity Safety
Safety planning and risk assessment requirements for field trips, research sites, and other academic activities off campus.
Programs
EHS administers comprehensive workplace safety programs meeting OSHA, EPA, and UNC System requirements. Each program includes policies, procedures, and training guidance for faculty, staff, and students.
Training & Resources
EHS provides training, reference materials, and regulatory guidance to help the campus community meet safety requirements and build a culture of safety.
Regulatory Training Requirements
Find out which OSHA-required and UNC System training courses apply to your role, organized by job type and department.
Google Classroom
Complete required EHS courses online at your own pace, with certificates available upon completion.
Online Safety Videos
A curated library of safety training videos for departmental orientations, safety meetings, and self-study.
Fact Sheets
Quick-reference safety fact sheets on common hazards and safe work practices — ready to print and post.
Forms
All EHS forms in one place: incident reports, inspection checklists, permit requests, and waste pickup requests.
Governance & Regulations
Federal and state regulations (OSHA, EPA, NC DENR) and UNC System policies governing EHS at UNC Asheville.
EHS Committee
The Environmental Health and Safety Committee is a shared governance body that advises university leadership on EHS policy, reviews campus safety performance, and promotes a culture of safety across all departments.
The source of authority for health, safety and environmental programs for all Universities within the North Carolina University System are:
EHS Staff
The EHS offices are located in Zeis Hall, Room 138. To speak with or arrange a meeting with an EHS staff member, call (828) 258-7692 or email directly.

Kevin Gibson
Environmental Health and Safety Professional
Office: 138 Zeis Hall
Phone: (828) 258-7692
Email: kgibson@unca.edu
Contact EHS
Zeis Hall, Room 138 · 1 University Heights, Asheville NC 28804
Non-emergency: (828) 258-7692 · Campus Police (emergency): (828) 232-5000